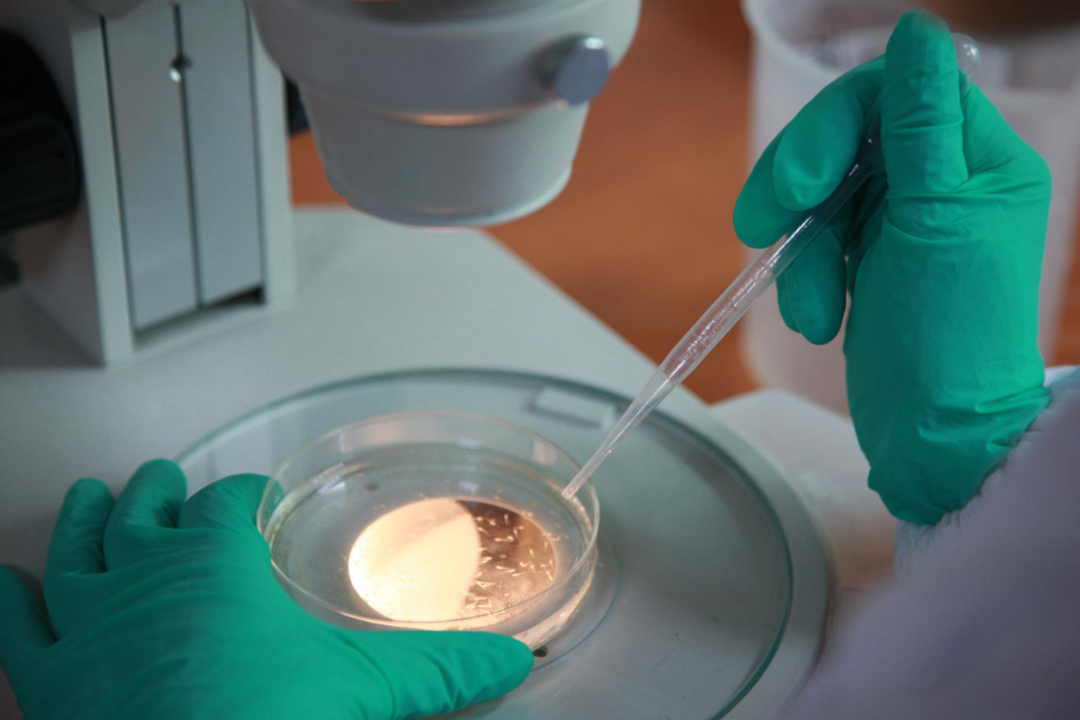
微信圖片_2025-10-14_141217_102.jpg

TOP
萬輪亮點|看環特生物李春啟如何“馴魚問道”,使斑馬魚從實驗室游向產業藍海
2025-10-21

錢塘江畔,潮聲如歌。濱江區這片熱土上,正涌動著新質生產力的澎湃浪潮。萬輪科技園園區企業——環特生物(浙江省重點專精特新企業),在它的斑馬魚實驗室里,一群身長約3厘米的“水中小白鼠”——斑馬魚,正晝夜不息地游弋,悄然改變著人類健康產業的研發路徑。
從臨床醫生到前世界衛生組織專家,從麻省理工學院研究員到中國斑馬魚技術應用產業化的開拓者,環特生物的創始人、總經理兼首席科學家李春啟博士帶領團隊,十五年磨一劍,以斑馬魚為利器,將其廣泛應用于藥物篩選、營養保健食品、化妝品功效與安全評價、環境污染毒性評估等多個關鍵領域,書寫了科技創新與產業應用深度融合的生動實踐。
李春啟博士的職業生涯充滿了跨界與融合。臨床醫學博士出身的他,在赴世界衛生組織工作前,曾擔任三甲醫院消化科副主任醫師、副教授。上世紀90年代,他在世界衛生組織國際癌癥研究機構工作三年,專注于肺癌、胃癌及炎癥疾病的防治研究。隨后,他遠赴麻省理工學院擔任研究員七年,并長期在全球首家斑馬魚技術公司負責其產業化應用……豐富的國際履歷為其創業奠定了堅實基礎。
2010年,正值中國從仿制藥大國向創新藥大國轉型的關鍵時期,他敏銳地意識到國內對斑馬魚技術的迫切需求,認為該技術具備巨大的產業化潛力。他毅然放棄海外優渥條件,回國創立環特生物。彼時,斑馬魚技術在國內尚屬空白,而他要做的正是“讓科學發現從論文里走出來”,使該技術大幅降低中國創新藥物的研發與篩選成本,縮短研發周期,提升成功率。
基于自身臨床醫學經驗,李春啟博士進一步發現:“與強調循證醫學的西方醫學相比,傳統中醫藥多依賴于經驗總結,而不是系統的科學證據支持。借助斑馬魚等技術,我們能夠構建一套針對中藥與營養保健食品的現代研發體系,以‘中醫藥+現代科技’深度融合為突破口,助力千年中藥煥發新生機!”
“水中小白鼠”斑馬魚,是源自于喜馬拉雅山南麓的熱帶淡水魚。自上世紀30年代被引入科研領域以來,斑馬魚憑借其獨特優勢逐漸嶄露頭角,已成為目前唯一適用于產業化應用的第三大模式生物。它通體透明,便于觀察,具有高可靠性(與人類基因相似度高達87%)、高效率(大部分評價檢測可在72小時內完成)、性價比突出(成本僅為傳統方法的十分之一甚至更低)等特點。目前,環特生物已成功建立220多種經過科學驗證、服務于多個行業的斑馬魚模型,在業內處于領先地位。

響應國家創新戰略號召,李博士帶領環特生物立足“循證功效研究”,持續提升斑馬魚技術的先進性與前瞻性,構建了“斑馬魚+類器官+皮膚外植體+哺乳動物+人體臨床”等多維生物技術平臺。通過多級循證功效遞進路徑,實現從體外到人體臨床、從功效安全到成分機制、從微觀到宏觀的全方位研究覆蓋,在營養健康食品、化妝品及中藥等領域,形成了涵蓋產品研發、原料篩選、功效安全評價、注冊申報、工藝驗證及新原料配方應用的完整技術解決方案,為循證營養評價提供堅實科技支撐與營銷助力,全鏈路賦能健康美麗產業發展!

面對“卡脖子”技術的國產替代挑戰,環特生物以“斑馬魚技術產業應用與生態建設的推動者”為使命,通過“設備+服務+標準”三位一體模式,推動斑馬魚技術從實驗室走向產業化,持續引領國產斑馬魚專用實驗設備的生態變革,為國產斑馬魚實驗設備樹立“硬科技+標準化”的創新典范!

今年以來,環特實驗室自主研發的養殖系統與智能分析系統(兩大類別、九款標桿設備),包括斑馬魚全景成像系統、斑馬魚3D行為分析系統、斑馬魚高通量2D行為分析系統、斑馬魚高通量工作站、斑馬魚毒理暴露系統、斑馬魚養殖系統、斑馬魚強迫游泳儀等,經譚建榮院士領銜的鑒定委員會認定達到“國際先進水平”。這不僅是中國生命科學產業鏈實現自主可控的重要一步,更超越了簡單的技術替代,有望引領全球斑馬魚研究新范式。

在這片數字與生命科學交融的前沿領域,環特生物以匠心打造設備新生態,助力中國實驗設備走向世界舞臺中央。從魚種活體保育到模型開發,從硬件配置到智慧運維,環特實驗室通過產業化實現規模化應用,并依托豐富的產業實踐持續升級,重塑斑馬魚實驗室平臺在各研究領域的建設與運營服務,為斑馬魚研究降本增效提供了切實解決方案,填補了斑馬魚專用設備領域的空白。
“科研不是短跑,而是馬拉松?!痹诶畲簡⒉┦康膱猿峙c引領下,環特生物在創新道路上從未停步。他們勇于創新,追求卓越:已發布22項團體標準,擁有100多項發明專利(其中41項已授權),發表SCI論文300余篇.....他們嚴謹務實,深耕不輟:8個新藥項目采用環特斑馬魚實驗數據向國家藥品監督管理局(NMPA)進行臨床試驗申報、作為核心技術方承擔杭州“亞運果蔬類食品農藥殘留非靶向快篩斑馬魚模型構建研究”,成果榮獲浙江省科學技術進步獎、廣西壯族自治區科學技術進步二等獎等……

從斑馬魚技術到“斑馬魚+類器官+皮膚外植體+哺乳動物+人體臨床”等多維生物技術平臺,一次次技術革新,一款款優質設備的推出,環特生物始終以“標準引領者”的姿態,推動行業規范化進程!
“濱江的土壤,讓我們滿懷夢想,敢想敢干!”作為杭州高新區(濱江)工商聯執委,李春啟博士深諳產學研融合之道。他先后推動環特生物與中國農科院質標所、中國藥科大學等共建聯合實驗室,將多維生物技術應用拓展至化妝品、中醫藥、環境毒理學評價等領域。他的愿景清晰而堅定:“我們要讓每一款具備競爭力的優質產品,都能通過我們的多維生物技術,彰顯其安全與功效!”這種“破界思維”,恰如濱江培育的“數字叢林”,創新者始終在突破邊界中探索新的可能。

從臨床醫生到科研先鋒,李春啟博士以“馴魚問道”的探索精神,引領著斑馬魚從實驗室的方寸水域,游向廣闊的商業藍海。
在他的實驗室中,新一代斑馬魚3D行為分析儀正靜靜運行,細致捕捉魚群每一個微妙的行為瞬間。這些看似微小的動態數據,最終將凝結為大健康與美麗產業中不可或缺的“安全密碼”,為消費者筑起一道看不見卻堅實可靠的防護之墻。
在這里,每一次技術突破,都在拓展人類認知與健康的邊界;每一份堅守與匠心,都在悄然推動美麗與健康產業的未來浪潮,鑄就一個屬于科技驅動的新時代。